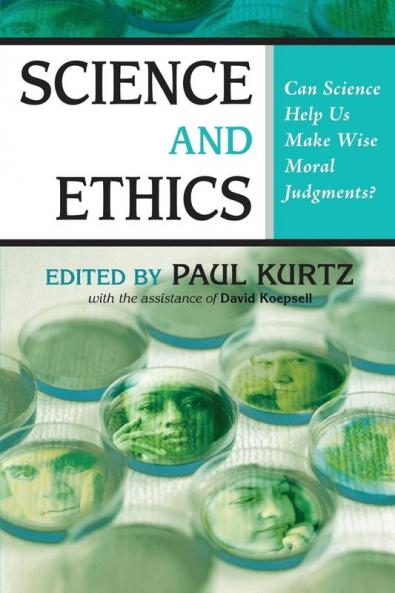

English
Paperback
₹1374
₹1938
29.1% OFF
(All inclusive*)
Delivery Options
Please enter pincode to check delivery time.
*COD & Shipping Charges may apply on certain items.
Review final details at checkout.
Looking to place a bulk order? SUBMIT DETAILS
Delivery Options
Please enter pincode to check delivery time.
*COD & Shipping Charges may apply on certain items.
Review final details at checkout.
About The Book
Description
Author(s)
In a world confronted by conflicting moral beliefs and values the question is often raised Can science help us to solve our moral problems? Many people today believe that moral principles are derived from religion. Their critics point out that the great religions often vehemently disagree about what is good bad right and wrong. On the other side of a great divide stand many who say that there are no ethical standards at all and that morality is merely a question of personal taste or cultural relativity. This volume presents a unique collection of authors who generally maintain that science can help us make wise choices and that an increase in scientific knowledge can help modify our ethical values and bring new ethical principles into social awareness. Among the thirty contributors to this volume are distinguished scientists and philosophers including Arthur Caplan Vern Bullough Mario Bunge Tom Flynn Susan Haack Richard Hull Scott Lilienfeld Ronald Lindsay Thomas Szasz Richard Taylor and others. Among the wide-ranging topics discussed are bio-genetic engineering stem cell research organ transplants human enhancement abortion euthanasia psychiatry and psychotherapy.Editor Paul Kurtz maintains that there is a modified form of naturalistic ethics that is directly relevant to both science and ethics and provides guidelines for our moral choices.
Details
ISBN 13
9781591025375
Publication Date
-05-06-2007
Pages
-360
Weight
-488 grams
Dimensions
-152x229x18.98 mm